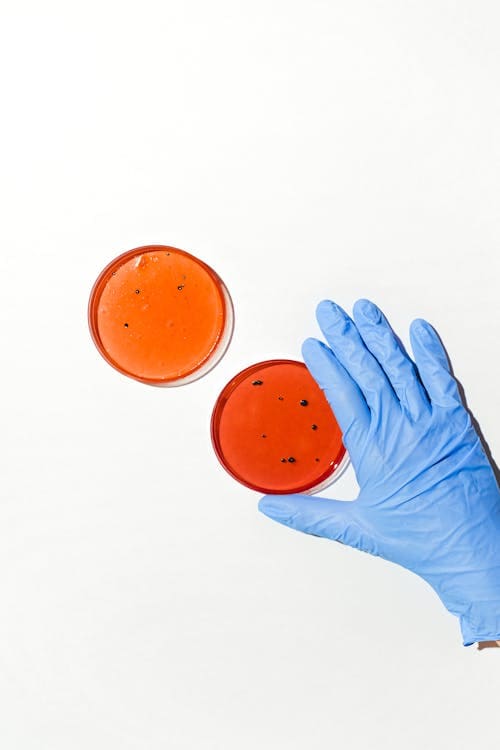

혹시 최근 대상포진 예방접종 가격에 대해 궁금하셨나요? 저도 주변에서 대상포진 접종을 고민하는 분들을 자주 보게 됩니다.
특히 50대 이상이 되면 건강 관리에 더 신경이 쓰이죠. 그런데 대상포진 예방접종 가격이 얼마나 하는지, 어느 백신이 좋은지, 지역별 차이는 어떤지 한눈에 아는 건 쉽지 않습니다.
이 글에서는 2025년 최신 기준으로 대상포진 예방접종 가격과 핵심 정보를 쉽고 정확하게 정리해 드립니다.
모바일로도 한눈에 확인할 수 있도록 표, 목록, 강조표현을 적극 사용했으니 꼭 끝까지 읽어보세요!
대상포진 예방접종 가격, 왜 꼭 알아야 할까요?



대상포진은 어릴 때 앓았던 수두 바이러스가 몸속에 남아 있다가, 면역력이 떨어지면 재활성화되어 발생합니다.
50대 이후에는 대상포진 발병률이 크게 높아지며, 심한 신경통이나 시력·청력 손상 같은 후유증이 남을 수 있습니다.
예방접종은 발병 자체를 줄이고, 혹시 발병하더라도 증상을 가볍게 만들어줍니다.
무엇보다 대상포진 예방접종 가격은 치료보다 훨씬 저렴하다는 점에서 경제적입니다.
- 수두를 앓았어도 대상포진 위험 있음
- 50세 이상은 면역력이 자연스럽게 감소
- 예방접종으로 후유증 위험도 크게 줄일 수 있음
- 대상포진 예방접종 가격은 치료비에 비해 부담 적음
하지만, 예방접종 가격이 병원별로 최대 15배 차이가 날 수 있다고 합니다.
꼭 잘 알아보시기 바랍니다.
2025년 대상포진 예방접종 가격 최신 비교

2025년 기준 대상포진 예방접종 가격은 백신 종류, 지역, 병원에 따라 다르게 책정됩니다.
현재 국내에서 사용되는 대표 백신은 조스타박스(Zostavax)와 싱그릭스(Shingrix)입니다.
조스타박스(Zostavax) 가격 및 특징



- 접종 방법: 1회 접종
- 예방 효과: 50~70%
- 대상포진 예방접종 가격: 13만~18만 원 *병원마다 상이합니다. 꼭 전화로 문의하시기 바랍니다.
- 가격이 상대적으로 저렴하며, 1회 접종으로 끝남
싱그릭스(Shingrix) 가격 및 특징



- 접종 방법: 2회 접종(2개월 간격)
- 예방 효과: 90% 이상
- 대상포진 예방접종 가격: 1회당 18만~22만 원(총 36만~44만 원) *병원마다 상이합니다. 꼭 전화로 문의하시기 바랍니다.
- 효과가 높고, 고령자·면역저하자에게 적극 권장
대상포진 예방접종 가격, 누가 꼭 확인해야 할까?



- 50세 이상 성인
- 당뇨, 신장·만성 폐질환자
- 항암·면역억제 치료 중인 분
- 과거 대상포진 이력이 있는 분
특히 고령자나 만성질환자라면 대상포진 예방접종 가격을 미리 알아보고, 예방 접종을 준비하는 것이 좋습니다.
대상포진 예방접종 가격 및 접종 전후 주의사항



- 접종 당일 과음, 과로, 격한 운동은 삼가세요.
- 접종 부위 통증, 미열 등은 대부분 1~3일 내 호전됩니다.
- 싱그릭스는 2개월 내 2차 접종을 꼭 완료해야 효과가 높습니다.
- 접종 후 20~30분간 병원에서 이상반응을 관찰하세요.
대상포진 예방접종 가격이 부담될 수 있지만, 부작용은 드물며 대부분 경미합니다.
접종 후 충분한 휴식을 취하는 것이 좋습니다.
대상포진 예방접종 가격, 무엇을 선택해야 할까?



조스타박스는 1회 접종, 저렴한 대상포진 예방접종 가격이 장점입니다.
반면 싱그릭스는 예방 효과가 매우 높으나, 대상포진 예방접종 가격이 상대적으로 높고 2회 접종이 필요합니다.
예방 효과와 대상포진 예방접종 가격을 모두 고려해 개인 건강상태와 예산에 맞는 백신을 선택하세요.
- 예방 효과 우선: 싱그릭스
- 비용 및 간편함 우선: 조스타박스
대상포진 예방접종 가격, 건강보험 적용될까?



현재 국내에서는 대상포진 예방접종 가격 전액이 본인 부담입니다.
건강보험이 적용되지 않으니, 사전에 비용을 충분히 확인하고 접종 계획을 세우는 것이 좋습니다.
한눈에 보는 대상포진 예방접종 가격 요약



- 조스타박스: 13만~18만 원(1회) *병원마다 상이합니다. 꼭 전화로 문의하시기 바랍니다.
- 싱그릭스: 36만~44만 원(2회) *병원마다 상이합니다. 꼭 전화로 문의하시기 바랍니다.
- 지역·병원별 가격 변동 있음
- 건강보험 미적용, 전액 본인부담
- 50세 이상·만성질환자에게 접종 권장
결론: 대상포진 예방접종 가격은 백신 종류와 지역, 병원에 따라 차이는 있지만, 예방 효과와 경제성을 함께 고려해 현명하게 선택하세요.
💡 자주 묻는 질문 (FAQ)
함께 읽으면 좋은 글
대상포진 초기증상 완벽 분석
혹시 갑자기 몸 한쪽에 통증이나 이상한 감각을 느낀 적 있으신가요? 대상포진 초기증상은 많은 분들이 감기나 단순 근육통으로 오해하기 쉽습니다. 특히 40~50대 이후, 바쁜 일상에 치여 자신을
ssoyaa.com
대상포진 치료방법 총정리 가이드
한 번 겪으면 잊기 힘든 통증, 바로 대상포진입니다.최근 들어 스트레스와 피로로 인해 젊은 층에서도 대상포진 환자가 늘고 있습니다.혹시 “대상포진 치료방법을 어떻게 시작해야 할지” 고
ssoyaa.com





